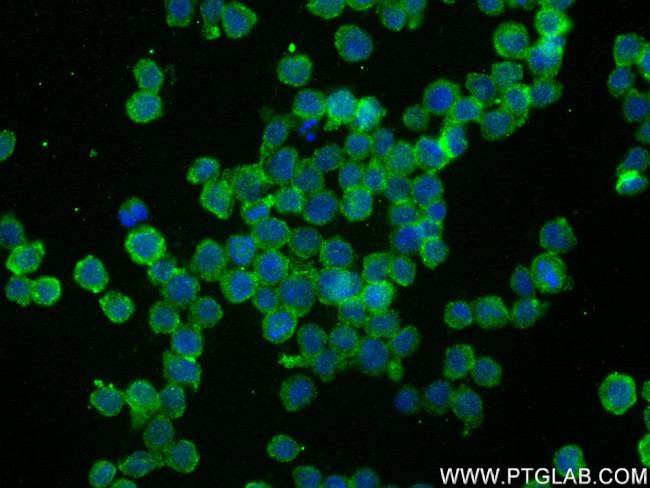
Piezo1 (extracellular domain) Antibody in Immunocytochemistry (ICC/IF)

Search
Proteintech
Piezo1 (extracellular domain) Recombinant Rabbit Monoclonal Antibody (4B15)
{{$productOrderCtrl.translations['antibody.pdp.commerceCard.promotion.promotions']}}
{{$productOrderCtrl.translations['antibody.pdp.commerceCard.promotion.viewpromo']}}
{{$productOrderCtrl.translations['antibody.pdp.commerceCard.promotion.promocode']}}: {{promo.promoCode}} {{promo.promoTitle}} {{promo.promoDescription}}. {{$productOrderCtrl.translations['antibody.pdp.commerceCard.promotion.learnmore']}}
产品信息
82625-4-RR
种属反应
宿主/亚型
Expression System
分类
类型
克隆号
抗原
偶联物
形式
浓度
纯化类型
保存液
内含物
保存条件
运输条件
产品详细信息
Immunogen sequence: SVVGVVNQPI DVTVTLKLGG YEPLFTMSAQ QPSIIPFTAQ AYEELSRQFD PQPLAMQFIS QYSPEDIVTA QIEGSSGALW RISPPSRAQM KRELYNGTAD ITLRFTWNFQ RDLAKGGTVE YANEKHMLAL APNSTARRQL ASLLEGTSDQ SVVIPNLFPK YIRAPNGPEA NPVKQLQPNE EADYLGVRIQ LRREQGAGAT GFLEWWVIEL QECRTDCNLL PMVIFSDKHH GAVRVHRAGH RQVRARILQR DLALHYVRGA AVRGPHPQAL PGHLPGAGDS GAGAGGGVVC QAHLPLPLTG DHDQVDS
靶标信息
Piezo1 is a pore-forming subunit of a mechanosensitive non-specific cation channel, and generates currents characterized by a linear current-voltage relationship that are sensitive to ruthenium red and gadolinium. Structurally, Piezo1 contains 36 transmembrane domains and functions as a homotetramer. Piezo1 plays a key role in epithelial cell adhesion by maintaining integrin activation through R-Ras recruitment to the ER, most probably in its activated state, and subsequent stimulation of calpain signaling. In the kidney, Piezo1 may contribute to the detection of intraluminal pressure changes and to urine flow sensing. Piezo1 acts as shear-stress sensor that promotes endothelial cell organization and alignment in the direction of blood flow through calpain activation and plays a key role in blood vessel formation and vascular structure in both development and adult physiology. The protein encoded by the Piezo1 gene is a mechanically-activated ion channel that links mechanical forces to biological signals. Defects in this gene have been associated with dehydrated hereditary stomatocytosis. Diseases associated with PIEZO1 include Dehydrated Hereditary Stomatocytosis with/without Pseudohyperkalemia And/Or Perinatal Edema and Lymphedema.
仅用于科研。不用于诊断过程。未经明确授权不得转售。
篇参考文献 (0)
生物信息学
蛋白别名: family with sequence similarity 38, member A; Membrane protein induced by beta-amyloid treatment; Mib; Piezo-type mechanosensitive ion channel component 1; Protein FAM38A
基因别名: DHS; FAM38A; KIAA0233; LMPH3; Mib; PIEZO1
UniProt ID: (Human) Q92508
Entrez Gene ID: (Human) 9780